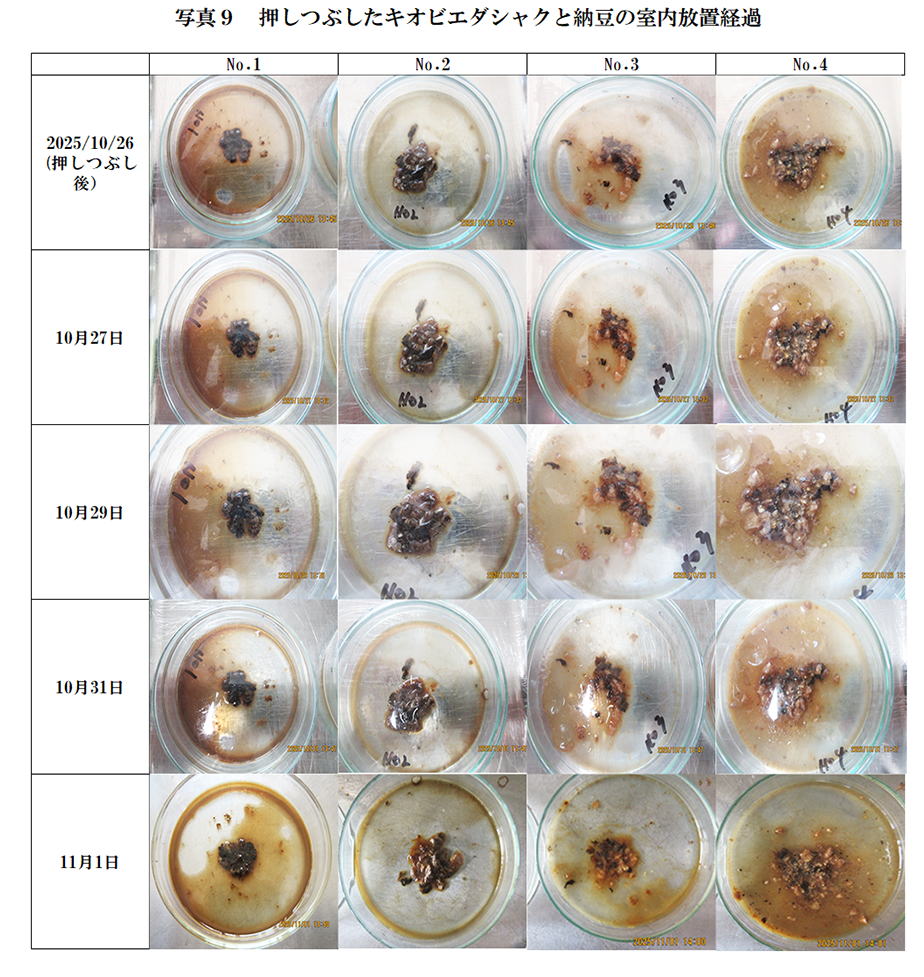

529. キオビエダシャクの幼虫に及ぼす納豆の影響 2025年11月13日
捕獲したキオビエダシャクの幼虫に市販納豆を混ぜ、幼虫が納豆菌により分解されるかどうかを見た。
使用した納豆を写真1に示した。

{写真2}
2025年9月18日に生きた幼虫をシャーレに入れ、納豆の添加量を変えて同じくシャーレに入れた。
さらに水道水を10mlずつ添加し、納豆から納豆菌が溶出するようにした。
No.1は納豆は添加せず、水のみを添加した。
最初動いいていた幼虫は1日経過後にはすべてのシャーレで動きを止めた。
9月21日の画像を見ると納豆を添加したものは幼虫の色が赤っぽくなった。

{写真3}
No.1とNo.2の幼虫は黒っぽくなりNo.3とNo4は赤っぽくなった。

{写真4}
No.2の幼虫の表面に白いカビが生えてきた。

{写真5}
納豆添加量の最も多いNo4が赤みを帯びており、形が崩れてきた。

{写真6}
No.3では幼虫が収縮しNo.4では膨潤してきた。

{写真7} 写真6と同じ状況である。

{写真8}
全てのシャーレで幼虫を収縮してきた。
特にNo.3の収縮は著しかった。

{写真9}
2025年10月26日に幼虫をスパ―テルで押しつぶして混合した。
いずれのシャーレも簡単にバラバラになったが、特にNo.3とNo.4は柔らかくなっていた。
表1に放置した幼虫表面の色の経過を示した、
No.2が白いのはカビが生えたためである。

図1に放置した幼虫表面のRGB経過をし目下。
カビが生えたNo2を除いて放置とともにRGBは低下し暗色化した。

10月5日以後RGBの大きな変化はなくなったので、それ以後の平均RGBを図2に比較した。
カビが生えたNo2を除いていずれも糖蜜色になった。
No.1,No.3,No4の間では納豆添加量の最も多いNo4のR値が高かった。

写真10に放置最終日の液部分の顕微鏡画像である。
No.1にもバクテリアが繁殖しているが、納豆を添加したNo.2,No.3,No4は納豆菌が凝集体を作っている。

図3は残渣の水洗浄の様子である。
No2だけは液部分を容易に分離できるほどの凝集体になっていた。
これはカビが繁殖したためであろう。
どうもNo.2は最初の水の添加量を間違えて少なくしてしまったようである。
そのために水分の少ないとことで生育するカビが生えたのではないかと推察した。

沪液のpHはNo.1(納豆無添加)は他に比べてやや高かった。(図4)
図5は沈澱RGB,図6は沪液RGBである。
図7には沈澱RGBと沪液RGBの相関を示した。
両者には正の相関がある。
納豆無添加のみが著しく暗色化していた。

写真11は洗浄沪過残渣の顕微鏡画像である。
納豆無添加のNo1には幼虫の組織成分が残っている。
No2にはカビの菌糸体が認められる。
No.3とNo4は幼虫の組織が壊れていることが示された。

以上よりキオビエダシャクの幼虫は納豆の添加により完全に分解されるにはいたらないものの、かなりの分解が進行していると言える。
分解された幼虫の成分は納豆菌の養分になっていると考えられる。
研究日誌の目次に戻る